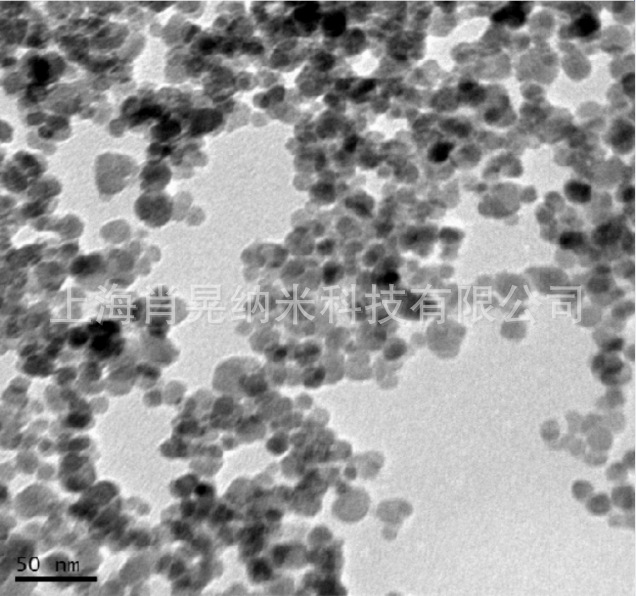
undefined

|





| 品牌 | 肖晃纳米 |
| 货号 | XH-Fe2O3-20 |
| 型号 | XH-Fe2O3 |
| 外观 | 用于各种塑料、橡胶、陶瓷、石棉制品的着色 |
| 包装规格 | 100g/500g/1kg/5kg |
| 纯度 | 99.9-99.999% |
| CAS编号 | 1309-37-1 |
| 别名 | 三氧化二铁 |
| 执行质量标准 | 企业标准 |
| 厂家(产地) | 上海 |
产品介绍:
产品特点:
微纳米三氧化二铁纯度高、粒径小、分布均匀,比表面积大、表面干净,无残余杂质,松装密度低,易于分散,耐高温(800℃不变色)。纳米氧化铁是一种新型的纳米材料,可应用于涂料、油漆、油墨和化工材料等领域。由于它的粒径仅为30nm,粒径非常小,因此它具有强紫外线吸收、高彩度、高着色力、高透明度等特性,且无毒、无味、耐温、耐酸碱,因而用途十分广泛。
产品参数:
| 产品归类 | 货号 | 平均粒径 | 纯度(%) | 晶型 | 颜色 |
| 纳米级 | XH-Fe2O3-30 | 30nm | >99.9 | α相/γ相 | 红色/红棕 |
| 纳米级 | XH-Fe2O3-50 | 50nm | >99.9 | α相/γ相 | 红色/红棕 |
| 纳米级 | XH-Fe2O3-80 | 80nm | >99.9 | α相/γ相 | 红色/红棕 |
| 亚微米级 | XH-Fe2O3-200 | 200nm | >99.9 | α相/γ相 | 红色 |
| 亚微米级 | XH-Fe2O3-300 | 300nm | >99.9 | α相/γ相 | 红色 |
| 亚微米级 | XH-Fe2O3-500 | 500nm | >99.9 | α相/γ相 | 红色 |
| 微米级 | XH-Fe2O3-001 | 1um | >99.9 | α相/γ相 | 红色 |
| 微米级 | XH-Fe2O3-003 | 3um | >99.9 | α相/γ相 | 红色 |
| 微米级 | XH-Fe2O3-005 | 5um | >99.9 | α相/γ相 | 红色 |
| 本公司可根据客户要求提供不同粒径和纯度的微纳米粉体定制生产 | |||||
产品应用:
1、由于铁红具有的耐温性能,因此适用于各种塑料、橡胶、陶瓷;适用于防锈漆、中低档涂料。适用于水泥制品、彩瓦的着色;在纤维着色浆、防伪涂层、静电复印、油墨方面的应用都十分广泛;
2、纳米氧化铁应用于化妆品中:纳米氧化铁的无毒性和吸收紫外能力极强性,适用化妆品行业;
3、纳米氧化铁应用于粉末涂料中:纳米氧化铁在温度300℃内颜色无变化,因此可以应用到无机涂料中,作为颜色调料;
4、在磁记录材料方面的应用:纳米氧化铁磁性材料加入涂料中,具有比重轻,对电磁波和声波有良好的吸收和衰减,对中红外波段有很强的吸收、耗散、屏蔽作用等特性;
5、在医学、生物领域中的应用;在催化方面、传感器方面的应用;
产品包装:
本品为充惰气包装,密封保存于干燥、阴凉的环境中,不宜暴露空气中,防受潮发生氧化团聚,影响分散性能和使用效果;包装数量可以根据客户要求提供,分装。
产品实拍:

电镜数据:

返回顶部